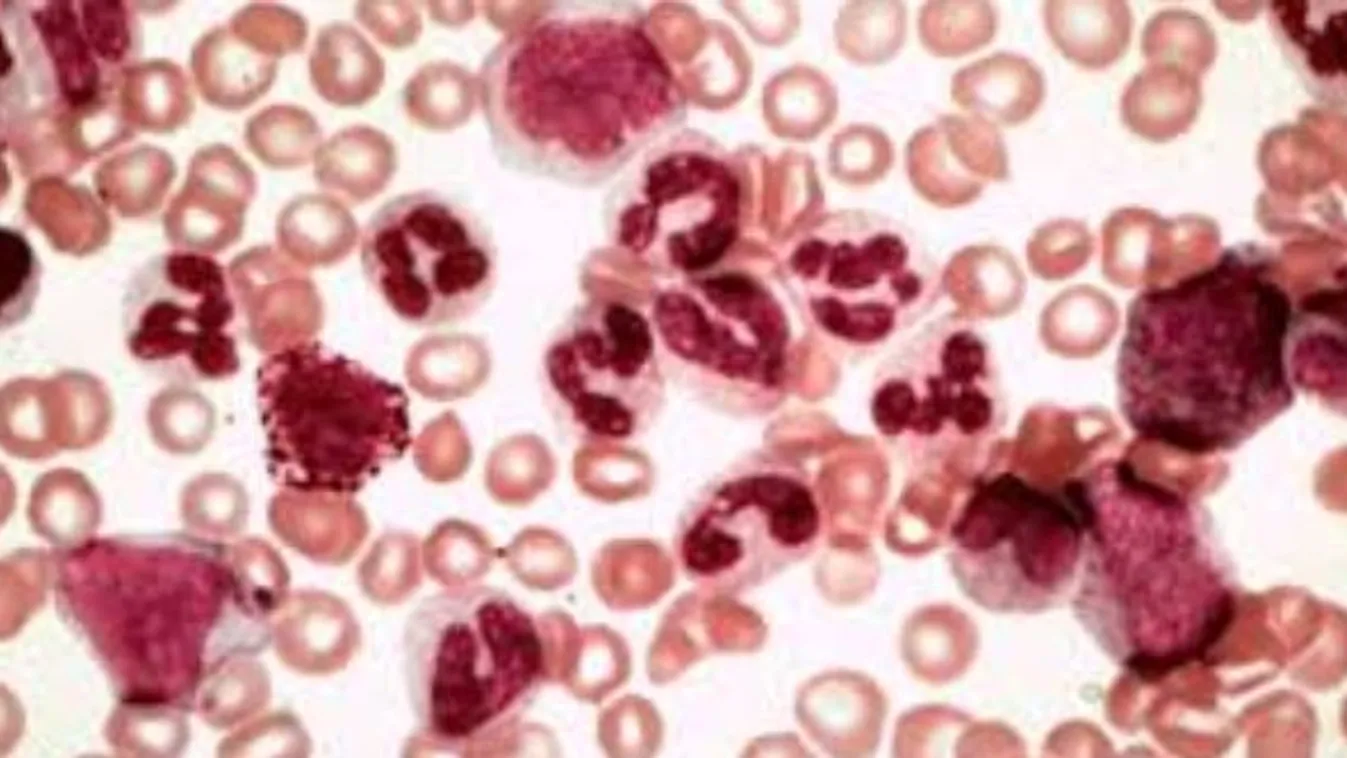
Magyar kutatás segítheti a leukémia kezelését

Egy nehezen gyógyítható, felnőttkori leukémiatípust kutattak.
A Bödör Csaba vezetésével működő kutatócsoport az MTA kiválósági programja, a Lendület program támogatásával számos külföldi partnerintézményt is magában foglaló kutatást indított, melyben több, klinikai jelentőséggel is bíró megfigyelést tettek. Kutatásaik középpontjában egy ibrutinib nevű új hatóanyag áll, melynek klinikai bevezetése áttörést hozott a nagy kockázatú CLL-es betegek kezelésében.
Legutóbbi kutatásukban a leukémiás sejtek és más immunsejtek ibrutinibkezelés nyomán megjelenő változásait vizsgálták, és egy speciális „molekuláris programot” azonosítottak a leukémiás sejtekben. Kiderült, hogy ezek a komplex molekuláris változások célzott kezelés hatására aktiválódnak, és bár valamennyi betegben egységes mintázatot mutatnak, egyes fázisaiknak a különböző betegekben eltér az időbeli lefolyása.
Ennek gyakorlati jelentősége lehet, mert így azonosíthatók a kezelésre gyorsabban és lassabban reagáló betegek, ami segítheti a célzott terápiás stratégiákat és akár új kombinációs kezeléseket is lehetővé tehet.
A kutatók szerint az általuk kidolgozott, legkorszerűbb módszerekre épülő eljárás a jövőben daganatok széles körében lehet alkalmas a különböző célzott terápiák hatására kialakuló molekuláris változások feltérképezésében – olvasható a közleményben.